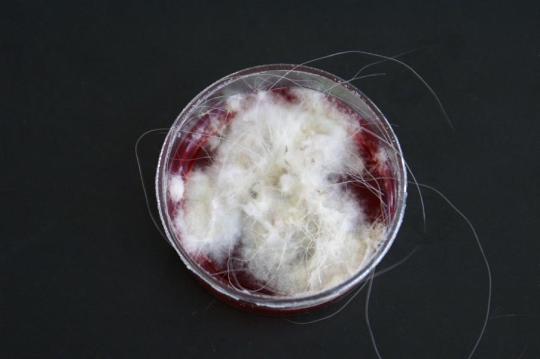
Demodikose

Den Besitzern ist aufgefallen, dass „Lana“ an verschiedenen Körperstellen Haare verliert und zunehmend unter Juckreiz leidet. Vor etwa einer Woche wurde ein neues Futter begonnen, und vor einigen Tagen hat die Tochter der Besitzer den Hund mit Babyöl „behandelt“.
Der Hund weist am ganzen Körper mottenfrassähnliche haarlose Stellen auf. Die Haut ist generell gerötet und stellenweise auch feucht; der Hund zeigt am ganzen Körper einen recht starken Juckreiz und auch entsprechende Kratzspuren. Der restliche Untersuch ist unauffällig.


Mehrere Ursachen kommen für die Hautveränderungen in Frage: Einerseits ist eine allergische Reaktion möglich (Futterallergie, möglicherweise auch eine Kontaktallergie auf Babyöl), welche meist mit einem deutlichen Juckreiz verbunden ist. Vorsichtshalber wird „Lana“ deshalb wieder das zuvor eingesetzte, gut vertragene Futter erhalten.
Neben allergischen Reaktionen kommen aber auch infektiöse Hautkrankheiten in Frage: Ein Befall mit Milben (z.B. Räudemilben, aber auch Demodex-Milben) oder Hautpilzen könnten ein ähnliches Symptombild hervorrufen. Deshalb wird einerseits eine Pilzkultur angelegt (welche negativ ausfällt), eine Blutuntersuchung auf Sarkoptes-Räudemilben durchgeführt (welche ebenfalls negativ ausfällt) und ein Hautgeschabsel angefertigt, um Demodex-Hautmilben nachzuweisen. Dazu wird an verschiedenen Hautstellen mit einer Skalpellklinge an der Haut gekratzt und das so gewonnene Material unter dem Mikroskop untersucht. Bei „Lana“ werden mit dieser Methode grosse Mengen an Milben nachgewiesen und so die Diagnose einer Demodikose gestellt, welche durch eine bakterielle Sekundärinfektion der Haut kompliziert wird und so einen heftigen Juckreiz hervorruft.

Als Vergleich: Positive Pilzkultur eines anderen Hundes (Farbumschlag des Nährmediums, Bildung einer Pilzkultur)
Der Hund erhält ein Antibiotikum, um den bakteriellen Hautinfekt zu bekämpfen, und ein Antihistaminikum gegen den Juckreiz. Ausserdem wird ein Shampoo verschrieben sowie ein Medikament, das auf die Haut aufgetragen wird und die Milben abtöten soll. Dem Hund geht es in der Folge besser, mit der Hautinfektion verschwinden auch der Juckreiz und die Hautrötung.

Ein Monat später hat sich die Situation aber wieder verschlechtert: „Lana“ hat wieder viele stark entzündete und nässende Hautpartien, der Haarverlust ist noch deutlicher, und auch der Juckreiz hat sich wieder verstärkt. Ein erneutes Hautgeschabsel dokumentiert noch grössere Mengen von Demodexmilben als vor einem Monat. Offensichtlich genügt die eingeleitete Milbentherapie nicht. Der Hund erhält eine Injektion mit einem Medikament, das das Immunsystem stimulieren sollte sowie ein Medikament gegen die Milben, das in flüssiger Form täglich einzunehmen ist und dadurch viel potenter wirkt als das auf die Haut aufgetragene Präparat. Jetzt endlich scheint sich die Therapie durchzusetzen, und in den nächsten Wochen wächst auf den haarlosen Hautarealen wieder Fell und der Juckreiz verschwindet. Ein erneutes Hautgeschabsel nach sieben Wochen zeigt, dass die Menge an Milben stark gesunken ist und alle Milben entweder tot oder verkrüppelt sind. Das Milbenmedikament wird in der Folge abgesetzt und Lana erholt sich vollständig.

Demodikose ist ein recht häufig auftretendes Problem bei Hunden. Die Milben werden meist während der Säugephase von der Mutter auf den Welpen übertragen und leben in den Haarbälgen (haarbildende Strukturen der Haut). Obwohl viele Tiere Träger dieser Haarbalgmilben sind, zeigen nur wenige davon die entsprechenden Symptome (Haarverlust, bei bakterieller Zweitinfektion auch Hautentzündung, Hautrötung und Juckreiz). Man vermutet, dass erst eine (vorübergehende) Schwächung des Immunsystemes ein Ausbrechen der Krankheit auslöst. In den meisten Fällen ist die Krankheit selbstlimitierend und heilt ohne weitere Behandlung aus; mit einem monatlich aufgetragenen Präparat gegen Parasiten kann dieser Vorgang beschleunigt werden.
Bei Junghunden kann sich die lokalisierte Form zu einer generalisierten Demodikose entwickeln. Ursache ist wahrscheinlich eine genetisch bedingte Störung der Hautabwehr, wobei die Schwächung des Immunsystems auch durch die Milben direkt erfolgt und somit abhängig von der Schwere des Befalls ist. In solchen Fällen kann eine Behandlung mittels antiparasitärer Bäder oder der oralen Verabreichung eines Medikamentes erfolgen. Beide Behandlungsarten können Nebenwirkungen bewirken und sind deshalb vorsichtig einzusetzen.
© Dr. med. vet. P. Müller / Lyssbachvet